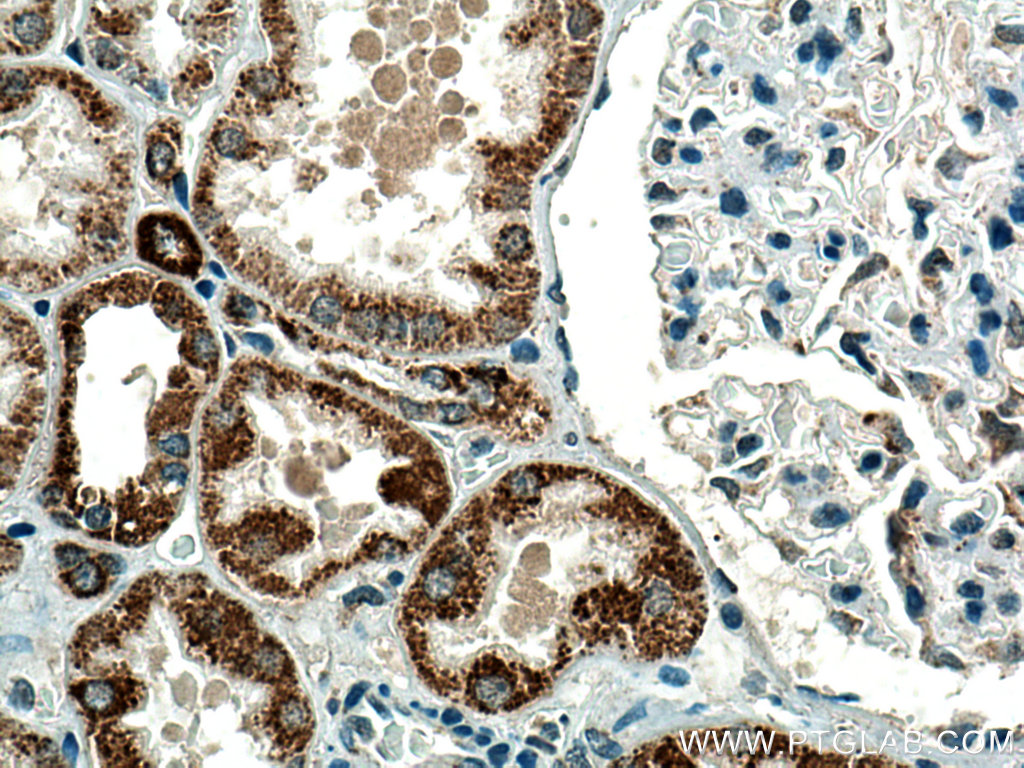

验证数据展示
经过测试的应用
| Positive WB detected in | mouse heart tissue, L02 cells, NIH/3T3 cells, mouse liver tissue, rat liver tissue, mouse skeletal muscle tissue, rat heart tissue |
| Positive IP detected in | L02 cells |
| Positive IHC detected in | human liver cancer tissue, human kidney tissue Note: suggested antigen retrieval with TE buffer pH 9.0; (*) Alternatively, antigen retrieval may be performed with citrate buffer pH 6.0 |
推荐稀释比
| 应用 | 推荐稀释比 |
|---|---|
| Western Blot (WB) | WB : 1:1000-1:8000 |
| Immunoprecipitation (IP) | IP : 0.5-4.0 ug for 1.0-3.0 mg of total protein lysate |
| Immunohistochemistry (IHC) | IHC : 1:50-1:500 |
| It is recommended that this reagent should be titrated in each testing system to obtain optimal results. | |
| Sample-dependent, Check data in validation data gallery. | |
产品信息
21988-1-AP targets PCCA in WB, IHC, IF, IP, ELISA applications and shows reactivity with human, mouse, rat samples.
| 经测试应用 | WB, IHC, IP, ELISA Application Description |
| 文献引用应用 | WB, IHC, IF, IP |
| 经测试反应性 | human, mouse, rat |
| 文献引用反应性 | human, mouse |
| 免疫原 |
CatNo: Ag17271 Product name: Recombinant human PCCA protein Source: e coli.-derived, PGEX-4T Tag: GST Domain: 344-703 aa of BC000140 Sequence: LVQEMIRVAKGYPLRHKQADIRINGWAVECRVYAEDPYKSFGLPSIGRLSQYQEPLHLPGVRVDSGIQPGSDISIYYDPMISKLITYGSDRTEALKRMADALDNYVIRGVTHNIALLREVIINSRFVKGDISTKFLSDVYPDGFKGHMLTKSEKNQLLAIASSLFVAFQLRAQHFQENSRMPVIKPDIANWELSVKLHDKVHTVVASNNGSVFSVEVDGSKLNVTSTWNLASPLLSVSVDGTQRTVQCLSREAGGNMSIQFLGTVYKVNILTRLAAELNKFMLEKVTEDTSSVLRSPMPGVVVAVSVKPGDAVAEGQEICVIEAMKMQNSMTAGKTGTVKSVHCQAGDTVGEGDLLVELE 种属同源性预测 |
| 宿主/亚型 | Rabbit / IgG |
| 抗体类别 | Polyclonal |
| 产品类型 | Antibody |
| 全称 | propionyl Coenzyme A carboxylase, alpha polypeptide |
| 别名 | Propionyl-CoA carboxylase alpha chain, mitochondrial, Propanoyl-CoA:carbon dioxide ligase subunit alpha, PCCase subunit alpha, EC:6.4.1.3 |
| 计算分子量 | 80 kDa |
| 观测分子量 | 70 kDa |
| GenBank蛋白编号 | BC000140 |
| 基因名称 | PCCA |
| Gene ID (NCBI) | 5095 |
| RRID | AB_2878963 |
| 偶联类型 | Unconjugated |
| 形式 | Liquid |
| 纯化方式 | Antigen affinity purification |
| UNIPROT ID | P05165 |
| 储存缓冲液 | PBS with 0.02% sodium azide and 50% glycerol, pH 7.3. |
| 储存条件 | Store at -20°C. Stable for one year after shipment. Aliquoting is unnecessary for -20oC storage. |
背景介绍
Propionyl-CoA carboxylase (PCC) catalyzes the biotin-dependent carboxylation of propionyl-CoA to D-methyl-malonyl CoA, a reaction that occurs in the mitochondrial matrix. PCC is involved in the catabolism of several essential amino acids (methionine, isoleucine, threonine and valine), as well as odd chain fatty acids and cholesterol. Deficiency of PCC results in propionic acidemia, a metabolic disorder characterized by severe metabolic ketoacidosis, vomiting, lethargy and hypotonia. PCC consists of nonidentical subunits (α and β) encoded by different genes (PCCA and PCCB, respectively). The αPCC cDNA contains an open reading frame of 2106 nucleotide bases and codes for a 702 amino acid polypeptide. The mature length subunit is 70 kDa and contains the biotin binding site.(PMID:8852656). This protein has 3 isoforms produced by alternative splicing with the molecular weight of 80 kDa, 77 kDa and 75 kDa. The full length protein has a transit peptide with 52 amino acids which will be removed in mature form. This antibody is specific to PCCA.
实验方案
| Product Specific Protocols | |
|---|---|
| IHC protocol for PCCA antibody 21988-1-AP | Download protocol |
| IP protocol for PCCA antibody 21988-1-AP | Download protocol |
| WB protocol for PCCA antibody 21988-1-AP | Download protocol |
| Standard Protocols | |
|---|---|
| Click here to view our Standard Protocols |
发表文章
| Species | Application | Title |
|---|---|---|
Nat Commun Dual mRNA therapy restores metabolic function in long-term studies in mice with propionic acidemia. | ||
J Cell Biol CLUH regulates mitochondrial metabolism by controlling translation and decay of target mRNAs. | ||
Mol Genet Metab Metabolic perturbations mediated by propionyl-CoA accumulation in organs of mouse model of propionic acidemia. | ||
Hum Gene Ther Effects of Adeno-associated Virus Serotype and Tissue-specific Expression on Circulating Biomarkers of Propionic Acidemia. | ||
Hum Gene Ther Long-term Sex-Biased Correction of Circulating Propionic Acidemia Disease Markers by Adeno-Associated Virus Vectors. | ||
Biology (Basel) In Situ Peroxidase Labeling Followed by Mass-Spectrometry Reveals TIA1 Interactome. |